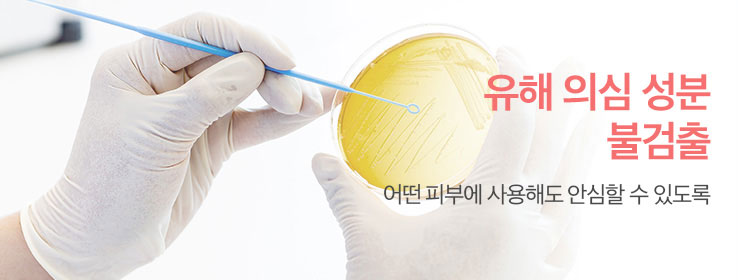

![[Paul Medison] Deep-red One-Time Towel _ 80 Sheets, 100% Natural Cotton Disposable Face Towel, Excellent Absorption Hypoallergenic _ Made in Korea [Paul Medison] Deep-red One-Time Towel _ 80 Sheets, 100% Natural Cotton Disposable Face Towel, Excellent Absorption Hypoallergenic _ Made in Korea](https://d3d3ajccnahae5.cloudfront.net/fit-in/1000x1000/image/catalog/Seller_1883/Product/Paul Medison_ Deep-red One-Time Towel/Paul Medison_ Deep-red One-Time Towel_th-20221207174502.jpg)
[Paul Medison] Deep-red One-Time Towel _ 80 Sheets, 100% Natural Cotton Disposable Face Towel, Excellent Absorption Hypoallergenic _ Made in Korea
0 reviews
0 sold. Only 999 remain
USD $5.90
USD $11.95
-51%
Negotiable (specific conditions to required)
Brands Paul_Medison
Product Code: Paul_Medison Deep-red One-Time Towel
Stock In Stock
Viewed 5735 times
Ship from South Korea
House Brand available (OEM, ODM, OBM)
Dropshipping available
Seller information


![[Paul Medison] Deep-red One-Time Towel _ 80 Sheets, 100% Natural Cotton Disposable Face Towel, Excellent Absorption Hypoallergenic _ Made in Korea [Paul Medison] Deep-red One-Time Towel _ 80 Sheets, 100% Natural Cotton Disposable Face Towel, Excellent Absorption Hypoallergenic _ Made in Korea](https://d3d3ajccnahae5.cloudfront.net/fit-in/270x270/image/catalog/Seller_1883/Product/Paul Medison_ Deep-red One-Time Towel/Paul Medison_ Deep-red One-Time Towel_th-20221207174502.jpg)





![[S2B] Niniz Jordi Erken Mac Stand Talk_Mobile Phone, Smartphone, Grip Talk, Mobile Phone Holder, Smartphone Grip, Mobile Phone Accessory_Made in Korea](https://d3d3ajccnahae5.cloudfront.net/fit-in/270x270/image/catalog/Seller_494/814_stob/thumb1-20230717082400-1689582240.jpg)

![[HAEMO] Aria Ceramic Glossy Spoon & Chopstick 5 Set – Premium High-Temperature Fired Cutlery, Modern Design, Individually Packaged" _ Made in Korea](https://d3d3ajccnahae5.cloudfront.net/fit-in/270x270/image/catalog/Seller_509/Products_1/HM_19/b1e002f629f6b8291bee749127749023-20250317071634-1742195794.jpg)
![[69SLAM] Man GetAway Long Board Short (Bottom) , Men's Swimwear, Beachwear, Short Pants, Swimming Trunks](https://d3d3ajccnahae5.cloudfront.net/fit-in/270x270/image/catalog/Seller_175/company/MEN R/getaway/94_shop1_536286-20210115014038.jpg)
![[VitaGRAM] USB Foldable Heated Seat Cushion for Hips, Heating Chair Pad VG-WS100-Temperature Settings with USB Port](https://d3d3ajccnahae5.cloudfront.net/fit-in/270x270/image/catalog/Seller_6462/Product/VitaGRAM_20/thumb-20240718064337-1721285019.jpg)

![[Paul Medison] Homme Water Whitening All In One Essence 211ml / 7.13 Fl.oz _ Men's Face Lotion, Whitening, Wrinkle Improvement _ Made in Korea](https://d3d3ajccnahae5.cloudfront.net/fit-in/270x270/image/catalog/Seller_1883/Product/Paul Medison_ Homme Water Whitening All In One Essence/download-20241101023329-1730428409.jpg )
![[WOOSUNG] Ten Commandments Metal Pen-Ballpoint Pen Writing Instrument Stationery Desk Accessory-Made in Korea](https://d3d3ajccnahae5.cloudfront.net/fit-in/270x270/image/catalog/Seller_433/products/Pen/10commandments/tencommandmentspen_01-20210426084333.jpg)
![[WOOSUNG] Gift Set Metal Book Mark (Cross)+Ten Commandments Metal Pen+Refill-Ballpoint Pen Writing Instrument Book Clip Desk Supplies - Made in Korea](https://d3d3ajccnahae5.cloudfront.net/fit-in/270x270/image/catalog/Seller_433/products/Giftset/cross_tencom_set/cross_tencom_set_01-20210427050840.jpg)
![[Wefun] Snack24 Mega Mixed Snack Set 32P – Extra-Large Korean Sweet & Savory Snack Box](https://d3d3ajccnahae5.cloudfront.net/fit-in/270x270/image/catalog/Seller_5354/Products/WF_29/a-20250922030721-1758510444.jpg)
![[thejoen] 50 pieces of sweat absorption hairbands (individual packaging)_Hypoallergenic, absorbent, golf, baseball, tennis, running, cycling, mountaineering, yoga, outdoor activities, disposable _Made in Korea](https://d3d3ajccnahae5.cloudfront.net/fit-in/270x270/image/catalog/Seller_5371/01_the/thumb5_1-20230706053705-1688621825.png)
![[thejoen] 20 pieces of sweat absorption hairbands (individual packaging)_Hypoallergenic, absorbent, golf, baseball, tennis, running, cycling, mountaineering, yoga, outdoor activities, disposable _Made in Korea](https://d3d3ajccnahae5.cloudfront.net/fit-in/270x270/image/catalog/Seller_5371/02_the/thumb5-20230706053919-1688621959.png)
![[thejoen] 20 pieces of sweat absorption hairbands (25 types)_Hypoallergenic, absorbent, golf, baseball, tennis, running, cycling, mountaineering, yoga, outdoor activities, disposable _Made in Korea](https://d3d3ajccnahae5.cloudfront.net/fit-in/270x270/image/catalog/Seller_5371/05_the/the_dbp13-20230718053231-1689658354.jpg)
![[Thejoen] 100 pieces of sweat absorption hairband (bulk) white, navy 1_hypoallergenic, absorbent, golf, baseball, tennis, running, cycling, mountaineering, yoga, outdoor activities, disposable _Made in Korea](https://d3d3ajccnahae5.cloudfront.net/fit-in/270x270/image/catalog/Seller_5371/04_the/thumb-20230904074743-1693813663.jpg)
![[Tendergarden] Morning Breeze Room Spray Nr.51 100ml - Fabric Woody Musk White Bergamot Floral Spray - Made in Korea](https://d3d3ajccnahae5.cloudfront.net/fit-in/270x270/image/catalog/Seller_6173/08_Tendergarden/thumb-1-20240122042204-1705897326.jpg)
![[Tender garden] Hydro Perfumed Body Wash 300ml-premium Moist natural oil body wash-Made in Korea](https://d3d3ajccnahae5.cloudfront.net/fit-in/270x270/image/catalog/Seller_6173/07_Tendergarden/thumb-1-20240119071655-1705648618.jpg)
![[Tender garden] Cozy Hug Purfumed Body Cream Nr.61 Sunset Lover 250g-Perfume Shea Butter Oil Moisturizing Body Cream-Made in Korea](https://d3d3ajccnahae5.cloudfront.net/fit-in/270x270/image/catalog/Seller_6173/14_Tendergarden/thumb-1-20240122065112-1705906272.jpg)